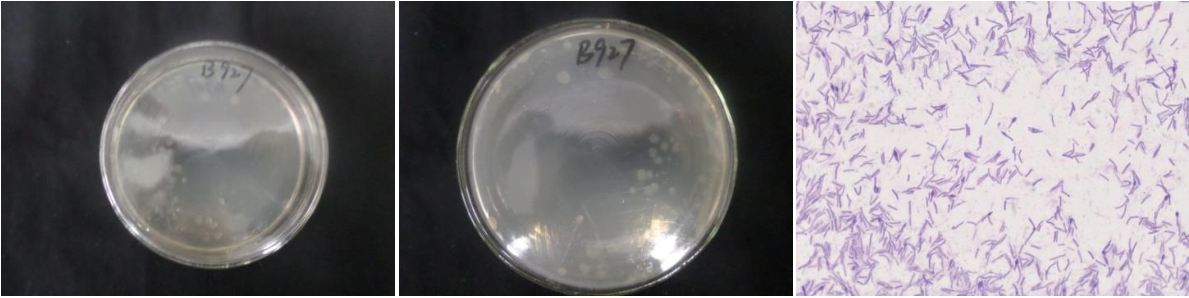

Loading...
| StrainNO | B927 |
| Classification | Bacillus |
| 16s rDNA sequence | ACCTGGCGGCGTGCCTATACATGCAAGTCGAGCGGGAAGTGAAAAGCTTGCTTTTCACTTCTAGCGGCGGACGGGTGAGTAAC ACGTGGGCAACCTGCCCTATAGACTGGGATAACACCGAGAAATCGGTGCTAATACCGGATAACCGAAGGAATCGCATGATTTCT TCTTAAAAGCTGGCGCAAGCTAGCACTATAGGATGGGCCCGCGGCGCATTAGCTAGTTGGTGAGGTAATGGCTCACCAAGGCGA CGATGCGTAGCCGACCTGAGAGGGTGATCGGCCACACTGGGACTGAGACACGGCCCAGACTCCTACGGGAGGCAGCAGTAGGGA ATCTTCCGCAATGGACGAAAGTCTGACGGAGCAACGCCGCGTGAGTGATGAAGGTTTTCGGATCGTAAAGCTCTGTTGTTAGGG AAGAACAAGTATCGTTCGAATAGGGCGGTACCTTGACGGTACCTAACGAGAAAGCCACGGCTAACTACGTGCCAGCAGCCGCGG TAATACGTAGGTGGCAAGCGTTGTCCGGAATTATTGGGCGTAAAGCGCGCGCAGGCGGTTTCTTAAGTCTGATGTGAAAGCCCA CGGCTCAACCGTGGAGGGTCATTGGAAACTGGGAAACTTGAGTGCAGAAGAGGAGAGTGGAATTCCACGTGTAGCGGTGAAATG CGTAGATATGTGGAGGAACACCAGTGGCGAAGGCGACTCTCTGGTCTGTAACTGACGCTGAGGCGCGAAAGCGTGGGGAGCGAA CAGGATTAGATACCCTGGTAGTCCACGCCGTAAACGATGAGTGCTAAGTGTTAGAGGGTTTCCGCCCTTTAGTGCTGCAGCAAA CGCATTAAGCACTCCGCCTGGGGA |
| Strain Morphology Photos | |
| Morphological Description | The morphology of Colony round;clam white;edge serrated;flat;center slightly convex;slippy;sticky;translucent;The morphology of strain:Rod;having spore;terminal spore |